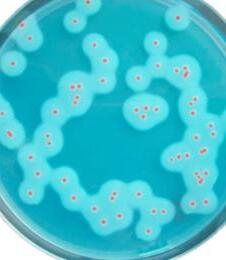

ScanDiagnostics
NR. 11, NOVEMBER

Sid 2-3
![]()
ScanDiagnostics
NR. 11, NOVEMBER

Sid 2-3

Brödets superhjälte:
Gluten är ett protein som finns i vissa spannmål, särskilt vete, råg och korn. Det är just gluten som ger degen dess spänst och gör att den kan jäsa och bli luftig.
• Gluten är det som ger bröd, kakor och pasta sin karaktäristiska struktur. Detta gör degen elastisk, så att den kan hålla fast i luftbubblorna som bildas under jäsningen. Utan gluten skulle vårt bröd vara platt och segt.
• Gluten fungerar också som ett bindemedel i många livsmedel. Det binder samman ingredienser och ger maten en bra konsistens.
• Gluten bidrar till den övergripande smaken och munkänslan hos många livsmedel. Enkelt uttryckt: Gluten är det som gör många av våra favoriträtter så läckra och tillfredsställande.
Kort sagt: Gluten er det, der gør mange af vores yndlingsfødevarer så lækre og tilfredsstillende. Desværre er der en del mennesker, som tåler gluten meget dårligt - de har cøliaki Derfor er der både lovgivning og Codex Alimentarius-standard, som beskriver, hvordan et indhold af gluten i en fødevare skal mærkes. Også hvis det er utilsigtet.
Vi erbjuder nu 2 nya kit. Båda kiten har betydande förbättringar som ökar enkelheten och noggrannheten för glutendetektion i livsmedels- och hygienanalys:
Baserat på R5-antikropp: Resultatjämförbarhet med våra andra glutentestsystem.
Enkel extraktionsprocedur med extraktionstablett.
Snabb analys: Säkerställer kvantitativa resultat inom 30 minuter (ELISA) eller 10 minuter (LFD).
Förbättrad kalibrering och validering: matriser användes som inte bara var förorenade med vete utan även med råg och korn, i enlighet med de senaste AOAC-riktlinjerna.
Ingen konvertering behövs längre: Kvantitativ analys av glutenrester från vete, råg och korn på grund av kalibrering mot gluten (ej gliadin!).
Vi tilbyder nu 2 nye kits. Begge kits har betydelige forbedringer, der øger letheden og nøjagtigheden af glutendetektion i fødevare- og hygiejneanalyser:
Färdiga reagenser som är långvariga och förenklar testprocessen.
• Baseret på R5-antistof: Resultatsammenlignelighed med vores øvrige glutentestsystemer.
• Enkel ekstraktionsprocedure ved brug af ekstraktionstablet.
• Hurtig analyse: Sikrer kvantitative resultater inden for 30 minutter (ELISA) eller 10 minutter (LFD).
• Forbedret kalibrering og validering: der er anvendt matricer, som ikke kun var forurenet med hvede, men også med rug og byg, i overensstemmelse med de seneste AOAC-retningslinjer.
• Ingen konvertering nødvendig længere: Kvantitativ analyse af glutenrester fra hvede, rug og byg på grund af kalibrering mod gluten (ikke gliadin!).
• Brugsklare reagenser, som er langtidsholdbare og forenkler testprocessen.

är ett R5-baserat ELISA-kit för kvantitativ analys av kontaminering med prolaminer från vete (gliadiner), råg (sekaliner) och korn (hordeiner) i livsmedel som bakverk, såser, chokladinnehållande desserter och kryddor.
Ingen korsreaktion upptäckt i 108 testade livsmedel.
LoD: 0,8 mg/kg gluten (vete, råg, korn)
LoQ: 3 mg/kg gluten (vete, råg, korn)
Mätområde: 1 mg/kg - 48 mg/kg Gluten


20% rabatt på RIDA®SMART BOX
Vad kan du förvänta dig?
Snabb och korrekt analys
Wi-Fi-anslutning för enkel export och lagring
Intuitiv drift med RIDA®SMART APP
Redo för mobilanalys med Android-enheter
är ett innovativt kit som gör det möjligt att kvantifiera mängden prolaminer från vete (gliadiner), råg (sekaliner) och korn (hordeiner) från både pinnprover, CIP-vatten och matprover, med hjälp av en Android-mobil eller en RIDA® SMART LÅDA.
Ingen korsreaktion upptäckt i 107 testade livsmedel.
LoD: Svabbar: 0,038 µg/ml gluten
CIP-vatten: 0,072 µg/ml gluten
Livsmedelsprover: 0,510 mg/kg gluten
LoQ: Svabbar: 0,20 µg/ml gluten
CIP-vatten: 0,25 µg/ml gluten
Livsmedelsprover: 3 mg/kg gluten
Måleområde: Svaber: 0.20 - 4 µg/mL gluten
CIP-vatten: 0,20 - 4 µg/ml gluten
Livsmedelsprover: 2 - 40 mg/kg gluten
Erbjudandet gäller till 31 december 2024. Få det du behöver till ett bra pris!!


Erik Björkegren
erik.bjorkegren@scandiagnostics.se
Tlf: 031-792 20 25
En nöt är inte bara en nöt. Inte allt vi kallar en nöt, är faktiskt en nöt.
Biokemi
Danmark
Cristiana@foodiagnostics.dk Telefon: 2594 8086
Ur en botanisk synvinkel finns det faktiskt bara ett fåtal "äkta nötter", inklusive hasselnötter, valnötter och söta kastanjer. Botaniskt sett är jordnötter baljväxter. Mandel, pekannötter, pistagenötter, cashewnötter och kokosnötter tillhör stenfrukter. Paranöt, macadamianöt, muskot och pinjenötter är frön, Sheanöten är ett bär.
Runi Nielsen
Færøerne
person till person. Dessutom är korsreaktioner utbredda bland nötallergiker. När det gäller lagstiftning delas nötter in i jordnötter och trädnötter.
Tonny NielEhsan Mirsharghi Mikrobiologi
Runi@foodiagnostics.dk Telefon: (298) 591667
Nötter är en av de vanligaste orsakerna till matallergier
Cirka 1 procent av befolkningen är allergisk mot nötter. Hasselnöts- och jordnötsallergier är särskilt utbredda, medan till exempel mandlar eller kokosnötter sällan utlöser allergiska reaktioner. Det går inte att uttala sig generellt om vilka nötter som är problematiska för personer med allergier, eftersom detta kan variera från
Danmark

Hygiejne & ECA
Danmark
Vilka nötter som ingår i gruppen trädnötter beror på det enskilda landets lagstiftning. Betydligt fler olika nötter (t.ex. kokosnötter och pinjenötter) ingår enligt amerikansk lagstiftning än i EU.
Tonny@foodiagnostics.dk Telefon: 4056 5659
Ehsan@foodiagnostics.dk Telefon: 2222 7592

Vi på Scandinavian Diagnostics är stolta över att presentera vår nya svenska webbplats, som är skräddarsydd för att möta behoven hos våra svenska kunder. Med en fräsch design och användarvänlig navigering är vi säkra på att vår nya webbplats kommer att förbättra din upplevelse och göra det enklare för dig att hitta den information och de produkter du behöver.
Webpage URL





Scandinavian Diagnostics kommer att vara stängt från och med 23/12-24 till och med 1/1-25
Sista utskick av kylvaror är 19 december 2024, för alla andra varor 20 dec 2024
Scandinavian Diagnostics AB Norra Ågaten 10 41664 Göteborg
Sverige
Tlf: 031-792 2020
Mail: order@scandiagnostics.se
www.scandiagnostics.se och anmäl dig till vårt digitala nyhetsbrev eller 'följ' oss på Facebook och LinkedIn





